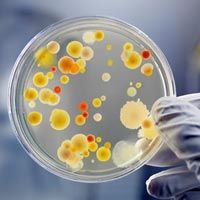
Microbial Culture

The Kosavampatti Business Directory in Namakkal connects buyers with trusted manufacturers, suppliers, exporters, and service providers. Known for its thriving commercial and industrial presence, Kosavampatti hosts businesses in sectors like pharmaceutical machines, medical supplies, industrial pumps, rollers, and more.
This directory makes it easy to find reliable local companies for sourcing products and services. Whether you need pharmaceutical machinery, medical supplies, or industrial pumps in Kosavampatti, our platform helps you compare and connect with top suppliers.
Our listings include company profiles, contact details, product descriptions, and service categories to support your business decisions. If you're a business owner in Kosavampatti, listing your company here boosts visibility, helping you reach customers in Namakkal and surrounding areas.

New Business Connections Fulfilling All Requirements

Kosavampatti, Namakkal
Deals in Fresh Fish Dry Fish Frozen Food...
Kosavampatti, Namakkal
Deals in Eggs, Mangos...

Kosavampatti, Namakkal
Deals in Bioculture- Bacteria For Effluent Treatment Plant And Sewage Treatment, Sewage T...

Kosavampatti, Namakkal
Deals in Automation System, Burglar Alarm Systems, Cash Counting Machine, CCTV Camera, Fi...
Kosavampatti, Namakkal
Deals in Agro Fertilizer Chemicals, Eggs, Fresh Vegetables, Leaf Plates, Ready Made Garme...
Kosavampatti, Namakkal
Deals in Plastic Scrap...
Kosavampatti, Namakkal
Deals in Tyre Coupling...
Kosavampatti, Namakkal
Deals in Horse Gram...
Kosavampatti, Namakkal
Deals in Plastic Nursery Pot...
Kosavampatti, Namakkal
Deals in Cow Milk...
Kosavampatti, Namakkal
Deals in Cotton Fabric Waste...
Kosavampatti, Namakkal
Deals in Organic Jaggery...
Kosavampatti, Namakkal
Deals in Used Cooking Oil...
Kosavampatti, Namakkal
Deals in Aluminium Foil Bag...
Kosavampatti, Namakkal
Deals in Chicken Egg...
The Kosavampatti Business Directory is an online listing platform that features manufacturers, suppliers, exporters, and service providers operating in Kosavampatti, Namakkal. It helps buyers discover verified local businesses and connect directly for products, services, and partnerships.
You can explore various business categories in the Kosavampatti Business Directory to find manufacturers, suppliers, and traders across multiple industries. Each listing includes company details, product information, and contact options to help you choose the right business in Namakkal.
Yes, businesses listed in the Kosavampatti Business Directory are reviewed before publication. Profiles may include verified contact details, company information, and product listings to ensure better trust and transparency for buyers in Namakkal.
Business owners in Kosavampatti, Namakkal can list their company by selecting the “List Your Business” or “Post Free Ad” option on the directory page. Adding your business helps improve online visibility and attract potential customers locally and across regions.
The Kosavampatti Business Directory helps B2B buyers compare multiple suppliers, manufacturers, and service providers in one place. It simplifies supplier discovery, saves time, and enables businesses to connect with reliable partners within Namakkal and nearby regions.